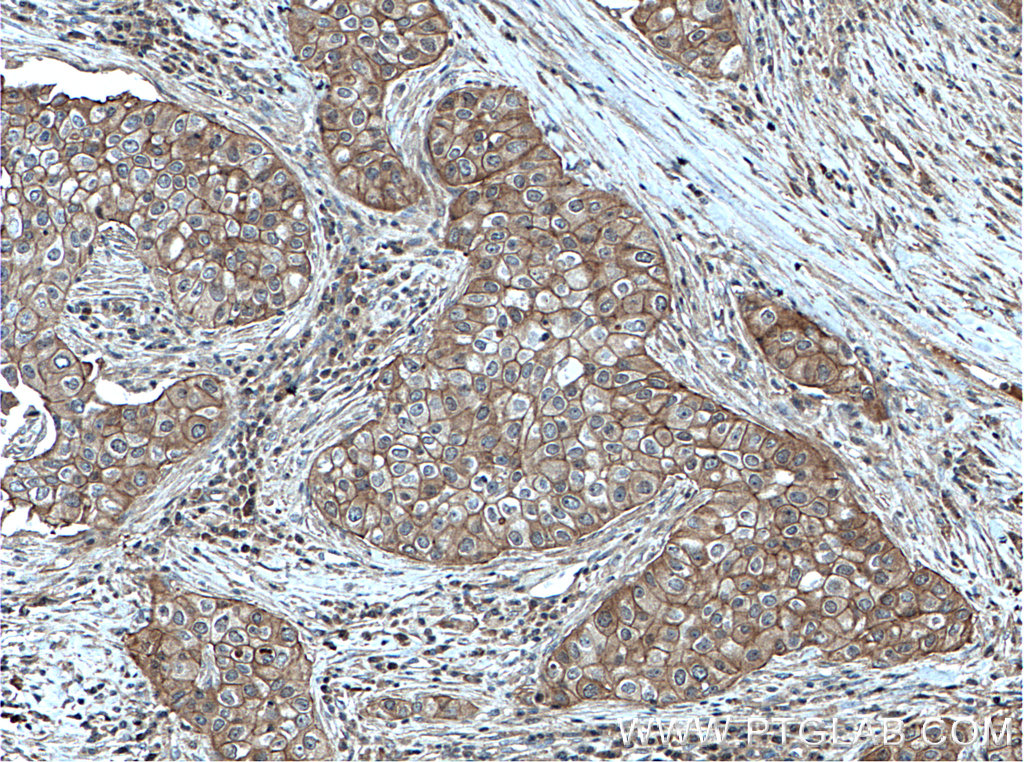
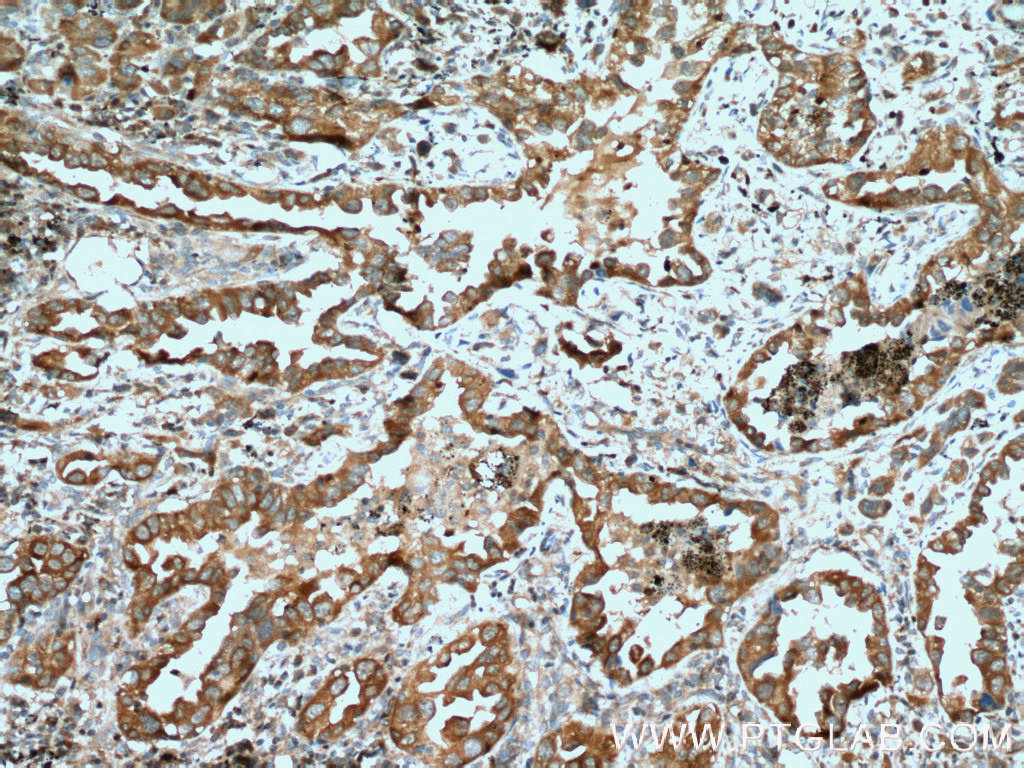

验证数据展示
经过测试的应用
| Positive WB detected in | HeLa cells, MCF-7 cells, LNCaP cells |
| Positive IP detected in | HeLa cells |
| Positive IHC detected in | human breast cancer tissue, human lung cancer tissue Note: suggested antigen retrieval with TE buffer pH 9.0; (*) Alternatively, antigen retrieval may be performed with citrate buffer pH 6.0 |
| Positive IF/ICC detected in | HeLa cells |
| Positive FC (Intra) detected in | HeLa cells |
推荐稀释比
| 应用 | 推荐稀释比 |
|---|---|
| Western Blot (WB) | WB : 1:2000-1:12000 |
| Immunoprecipitation (IP) | IP : 0.5-4.0 ug for 1.0-3.0 mg of total protein lysate |
| Immunohistochemistry (IHC) | IHC : 1:50-1:500 |
| Immunofluorescence (IF)/ICC | IF/ICC : 1:200-1:800 |
| Flow Cytometry (FC) (INTRA) | FC (INTRA) : 0.20 ug per 10^6 cells in a 100 µl suspension |
| It is recommended that this reagent should be titrated in each testing system to obtain optimal results. | |
| Sample-dependent, Check data in validation data gallery. | |
产品信息
13883-1-AP targets PKC Iota in WB, IHC, IF/ICC, FC (Intra), IP, CoIP, ELISA applications and shows reactivity with human samples.
| 经测试应用 | WB, IHC, IF/ICC, FC (Intra), IP, ELISA Application Description |
| 文献引用应用 | WB, IHC, IF, IP, CoIP |
| 经测试反应性 | human |
| 文献引用反应性 | human, mouse, chicken |
| 免疫原 |
CatNo: Ag4990 Product name: Recombinant human PRKCI protein Source: e coli.-derived, PGEX-4T Tag: GST Domain: 238-587 aa of BC022016 Sequence: SSLGLQDFDLLRVIGRGSYAKVLLVRLKKTDRIYAMKVVKKELVNDDEDIDWVQTEKHVFEQASNHPFLVGLHSCFQTESRLFFVIEYVNGGDLMFHMQRQRKLPEEHARFYSAEISLALNYLHERGIIYRDLKLDNVLLDSEGHIKLTDYGMCKEGLRPGDTTSTFCGTPNYIAPEILRGEDYGFSVDWWALGVLMFEMMAGRSPFDIVGSSDNPDQNTEDYLFQVILEKQIRIPRSMSVKAASVLKSFLNKDPKERLGCLPQTGFADIQGHPFFRNVDWDMMEQKQVVPPFKPNISGEFGLDNFDSQFTNERVQLTPDDDDIVRKIDQSEFEGFEYINPLLMSAEECV 种属同源性预测 |
| 宿主/亚型 | Rabbit / IgG |
| 抗体类别 | Polyclonal |
| 产品类型 | Antibody |
| 全称 | protein kinase C, iota |
| 别名 | PRKCI, aPKC lambda/iota, aPKC-lambda/iota, Atypical protein kinase C-lambda/iota, DXS1179E |
| 计算分子量 | 68 kDa |
| 观测分子量 | 67 kDa |
| GenBank蛋白编号 | BC022016 |
| 基因名称 | PKC Iota |
| Gene ID (NCBI) | 5584 |
| RRID | AB_2171777 |
| 偶联类型 | Unconjugated |
| 形式 | Liquid |
| 纯化方式 | Antigen affinity purification |
| UNIPROT ID | P41743 |
| 储存缓冲液 | PBS with 0.02% sodium azide and 50% glycerol, pH 7.3. |
| 储存条件 | Store at -20°C. Stable for one year after shipment. Aliquoting is unnecessary for -20oC storage. |
背景介绍
The atypical protein kinase C isoform PRKC iota (PRKCI) is a member of the protein kinase C (PKC) family of serine/threonine protein kinases. PKC family comprises at least eight members, which are differentially expressed and are involved in a wide variety of cellular processes. PRKC iota is calcium-independent and phospholipid-dependent. It is not activated by phorbolesters or diacylglycerol. This kinase can be recruited to vesicle tubular clusters (VTCs) by direct interaction with the small GTPase RAB2, where this kinase phosphorylates glyceraldehyde-3-phosphate dehydrogenase (GAPD/GAPDH) and plays a role in microtubule dynamics in the early secretory pathway. This kinase is found to be necessary for BCL-ABL-mediated resistance to drug-induced apoptosis and therefore protects leukemia cells against drug-induced apoptosis. PRKC iota plays a key role in cell proliferation, differentiation, and carcinogenesis, and it has been shown to be a human oncogene.
实验方案
| Product Specific Protocols | |
|---|---|
| FC protocol for PKC Iota antibody 13883-1-AP | Download protocol |
| IF protocol for PKC Iota antibody 13883-1-AP | Download protocol |
| IHC protocol for PKC Iota antibody 13883-1-AP | Download protocol |
| IP protocol for PKC Iota antibody 13883-1-AP | Download protocol |
| WB protocol for PKC Iota antibody 13883-1-AP | Download protocol |
| Standard Protocols | |
|---|---|
| Click here to view our Standard Protocols |
发表文章
| Species | Application | Title |
|---|---|---|
Mol Cancer circPARD3 drives malignant progression and chemoresistance of laryngeal squamous cell carcinoma by inhibiting autophagy through the PRKCI-Akt-mTOR pathway.
| ||
Development Coupling of apical-basal polarity and PCP to interpret the Wnt signaling gradient and orient feather branch.
| ||
Mol Med Paired protein kinases PRKCI-RIPK2 promote pancreatic cancer growth and metastasis via enhancing NF-κB/JNK/ERK phosphorylation | ||
Int J Biol Sci Poly (ADP-ribose) polymerase 1 (PARP1) inhibition promotes pulmonary metastasis of osteosarcoma by boosting ezrin phosphorylation. | ||
Onco Targets Ther Protein kinase C-iota-mediated glycolysis promotes non-small-cell lung cancer progression.
| ||
Antioxidants (Basel) PKCiota Inhibits the Ferroptosis of Esophageal Cancer Cells via Suppressing USP14-Mediated Autophagic Degradation of GPX4
|